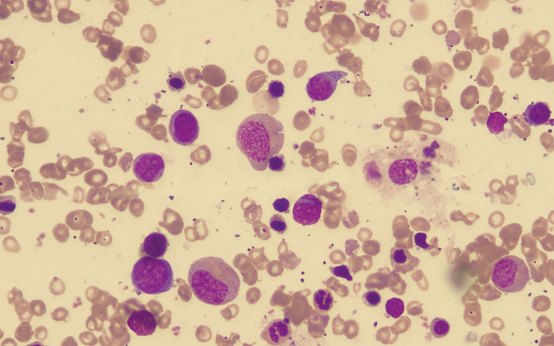
#3.png #3.png
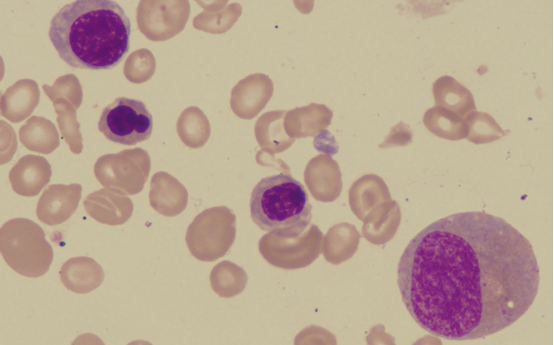
#5.png #5.png
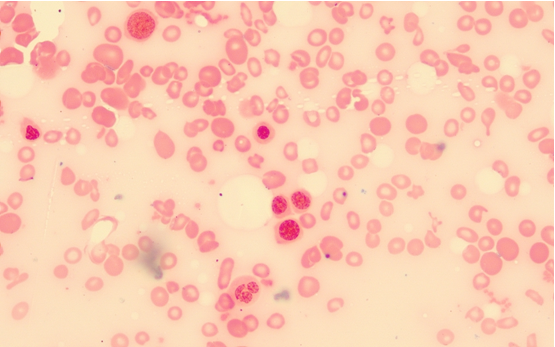
#8.png #8.png

病例簡史:
老年女性,83歲,于20天前無明顯誘因下出現(xiàn)四肢乏力、面色蒼白,活動(dòng)后有氣促,無頭暈、頭痛,無發(fā)熱、畏寒,無心悸、胸悶,無腹痛、腹脹,未予重視;4天前患者訴癥狀加重,伴有心悸、胸悶,納差、排黑便1次,無腹痛、腹脹,無排血便、惡心、嘔吐,經(jīng)休息后癥狀無緩解。既往行胃畢II式切除術(shù),伴關(guān)節(jié)腫痛多年。
體檢:
T 36.6℃,P 126次/分,R 20次/分,BP 149/55mmHg。神志清晰,貧血貌,呼吸平穩(wěn),問答切題,口齒清晰,查體合作。雙眼瞼結(jié)膜蒼白,全身皮膚粘膜無黃染,無瘀點(diǎn)瘀斑,無出血點(diǎn),全身淺表淋巴結(jié)無腫大,頸軟,無抵抗,頸靜脈無充盈,氣管居中,胸部外形正常,叩診雙肺呈清音,雙側(cè)呼吸運(yùn)動(dòng)對(duì)稱。雙肺呼吸音清,雙肺未聞及濕啰音、干啰音,HR:126次/分,律齊,雜音未聞及,腹部平坦,無壓痛,無反跳痛,肝脾肋下未及,雙下肢無浮腫,病理征陰性。
輔助檢查:
血常規(guī):白細(xì)胞 8.69 *109/L ,紅細(xì)胞 2.01 *1012/L ↓,血紅蛋白 32.0 g/l ↓,血小板 186.0 *109/L ,紅細(xì)胞壓積 0.124 ↓,平均血紅蛋白量MCH 15.9 pg ↓,平均血紅蛋白濃度 258.0 g/l ↓,平均紅細(xì)胞體積MCV 61.7 fl ↓。網(wǎng)織紅細(xì)胞絕對(duì)值0.028 *1012/L ↓,網(wǎng)織紅細(xì)胞千分比10.9‰ 。
尿常規(guī):無異常。
便常規(guī):潛血弱陽性。
Coombs試驗(yàn)(直接、間接):均陰性。
生化:血清鐵2.8umol/l ↓,總鐵結(jié)合力63.5umol/l,不飽和鐵結(jié)合力60.7umol/l↑,鐵飽和度0.04↓,轉(zhuǎn)鐵蛋白2.9g/l,總蛋白52.5g/l↓,白蛋白33.8g/l,球蛋白18.7g/l,總膽紅素25.8umol/l↑,直接膽紅素9.6umol/l↑,間接膽紅素16.2ummol/l,總膽汁酸19.6umol/l↑,余未見明顯異常。
免疫:類風(fēng)濕因子65.9IU/ml↑,抗核抗體(陽性),著絲點(diǎn)蛋白B(陽性)。
貧血三項(xiàng):鐵蛋白5.00ug/l↓,維生素B12為1117.5pmol/l↑,葉酸23.83ug/l。
腹部彩超:未見明顯異常。
胃鏡:1、殘胃炎;2、畢II式術(shù)后改變。
腸鏡:1.盲腸息肉 2.直腸息肉 3.痔。
病例分析:
通過外周血常規(guī)檢查分析,患者處于重度貧血狀態(tài),根據(jù)紅細(xì)胞相關(guān)參數(shù)可歸類至小細(xì)胞低色素性貧血大類。這類貧血中臨床上常見的有缺鐵性貧血、珠蛋白生成障礙性貧血、鐵粒幼細(xì)胞性貧血等。分析生化結(jié)果及鐵蛋白,考慮患者缺鐵性貧血可能性大。鐵蛋白、血清鐵、鐵飽和度降低,總鐵結(jié)合力、不飽和鐵結(jié)合力、轉(zhuǎn)鐵蛋白正;蛏叻从吵鰴C(jī)體缺鐵的狀態(tài),也可基本排除鐵粒幼細(xì)胞性貧血。鐵粒幼細(xì)胞性貧血是指機(jī)體本身不缺鐵、而幼紅細(xì)胞利用鐵障礙導(dǎo)致小細(xì)胞低色素性貧血,此種病理狀態(tài)下血清鐵、鐵飽和度、鐵蛋白等一般不降低。針對(duì)于貧血的病因分析,最常規(guī)也非常有實(shí)用意義的實(shí)驗(yàn)室檢查就是外周血形態(tài)分析。通過外周血涂片(圖1、2)我們可以發(fā)現(xiàn),成熟紅細(xì)胞大小不一,異形明顯,可見中央淡染區(qū)擴(kuò)大、面包圈樣紅細(xì)胞,未見珠蛋白生成障礙性貧血相關(guān)的靶形等異常形態(tài)。但是同時(shí)我們還可以發(fā)現(xiàn),巨大成熟紅細(xì)胞(非體積偏大的嗜多色網(wǎng)織紅細(xì)胞)、分葉過多(分葉大于6葉)的中性粒細(xì)胞多見。該形態(tài)異常易見于巨幼細(xì)胞性貧血患者血象。但是該患者葉酸含量正常,且維生素B12較高以至于超出檢測線性范圍。于是矛盾就發(fā)生了,怎么回事呢?是什么原因?qū)е碌耐庵苎<?xì)胞分葉過多及出現(xiàn)巨紅細(xì)胞呢?

圖1

圖2
為進(jìn)一步確診貧血的病因,建議臨床進(jìn)行骨髓穿刺涂片檢查。雖然,結(jié)合外周血常規(guī)、生化檢查、鐵蛋白、外周血形態(tài)分析、患者胃切除病史及胃腸鏡檢查、便潛血陽性檢查結(jié)果能得出缺鐵性貧血的診斷。但是外周血其他的形態(tài)異常不能單以缺鐵來解釋。為排除惡性血液病及地中海貧血等其他病因,臨床擬進(jìn)行骨髓穿刺行流式、地貧基因、涂片形態(tài)分析。骨髓涂片形態(tài)如圖3、4、5、6,可見有核細(xì)胞增生活躍,G=24.50%、E=66.00%、G/E=0.4:1;粒系比例相對(duì)減低,可見巨幼變桿狀核及晚幼粒細(xì)胞,易見多分葉中性粒細(xì)胞;紅系比例明顯增高,以中晚紅為主,可見巨幼變、花瓣核、含豪焦小體幼紅細(xì)胞,成熟紅細(xì)胞大小不一,異形明顯,可見中央淡染區(qū)擴(kuò)大、面包圈樣紅細(xì)胞、巨大紅細(xì)胞。涂片鐵染色(圖7、8)檢查可見,圖7外鐵(陰性),圖8內(nèi)鐵(陽性率0%)。流式細(xì)胞學(xué)檢查未見異常。地貧基因突變檢查未見異常。
圖3

圖4
圖5

圖6

圖7
圖8
從骨髓涂片結(jié)果來分析,可以發(fā)現(xiàn)缺鐵病因得到進(jìn)一步確證,同時(shí)也驗(yàn)證了可能合并巨幼細(xì)胞性貧血的外周血形態(tài)分析初步結(jié)論。那么,一個(gè)矛盾點(diǎn)是B12及葉酸均正常;颊呤欠袢朐呵敖邮苓^補(bǔ)充治療?檢驗(yàn)醫(yī)師的的作用此刻就可以發(fā)揮了,詳細(xì)了解患者現(xiàn)狀及既往病史、治療用藥史,及時(shí)與主管醫(yī)師進(jìn)行交流與溝通,共同研究患者病因、病情變化及轉(zhuǎn)歸。通過與主管醫(yī)師探討病情、交換意見,同時(shí)共同查房、詳細(xì)補(bǔ)充臨床病史及用藥信息發(fā)現(xiàn),患者由于行胃畢II式切除術(shù)后經(jīng)常伴有肢體麻木的異樣感覺,于是尋求便民診所幫助,長期服用甲鈷胺(維生素12為有效成分)緩解癥狀,因此進(jìn)行入院檢測時(shí)B12血液含量不低反而升高?紤]到患者肢體麻木可能由于胃切除術(shù)后B12吸收欠佳導(dǎo)致含量缺乏而引起神經(jīng)系統(tǒng)癥狀。同時(shí),患者由于多年關(guān)節(jié)腫痛考慮診斷類風(fēng)濕性關(guān)節(jié)炎,于便民診所長期服用甲氨蝶呤等拮抗葉酸的藥物。匯總這些信息可以得出結(jié)論,患者由于胃切除術(shù)后飲食及吸收受影響,同時(shí)殘胃炎、腸道息肉、痔等致慢性消化道失血丟鐵導(dǎo)致缺鐵性貧血;胃切除術(shù)后由于胃體壁細(xì)胞減少,內(nèi)因子的分泌量隨之減少可導(dǎo)致B12吸收欠佳,血清B12含量降低誘發(fā)貧血或肢體麻木等神經(jīng)系統(tǒng)癥狀;患者長期口服甲鈷胺可干擾入院血清B12的檢測結(jié)果;患者關(guān)節(jié)腫痛,類風(fēng)濕因子及多項(xiàng)自身抗體陽性提示不排除類風(fēng)濕關(guān)節(jié)炎等自身免疫性疾病,患者長期服用低劑量甲氨蝶呤可拮抗葉酸的生理作用,導(dǎo)致血細(xì)胞巨幼變及粒細(xì)胞過分葉狀態(tài)。因此患者可能并存缺鐵性貧血及藥物導(dǎo)致的巨幼細(xì)胞性貧血。由于缺鐵性貧血影響了MCV的計(jì)算結(jié)果,導(dǎo)致血常規(guī)數(shù)據(jù)提示巨幼細(xì)胞性貧血的可能性被掩蓋,同時(shí)由于患者自身伴隨疾病及治療用藥的影響,針對(duì)于巨幼貧的B12、葉酸檢測也未能給出提示性意義。此時(shí),直觀的血細(xì)胞形態(tài)分析顯得尤為重要了。本例中,檢驗(yàn)醫(yī)師結(jié)合細(xì)胞形態(tài)及詳細(xì)的病史用藥史提示診斷極易忽略的巨幼細(xì)胞性貧血狀態(tài),可幫助主管醫(yī)生多方面權(quán)衡,進(jìn)行更全面的治療。
因此,在完善病史及用藥信息、結(jié)合各項(xiàng)實(shí)驗(yàn)室檢查后,檢驗(yàn)醫(yī)師協(xié)助臨床得出缺鐵性貧血合并巨幼細(xì)胞性貧血的診斷,建議患者在針對(duì)貧血治療的同時(shí),咨詢風(fēng)濕免疫科進(jìn)行科學(xué)、規(guī)范的抗類風(fēng)濕關(guān)節(jié)炎的治療,以避免缺鐵性貧血糾正后使得巨幼細(xì)胞性貧血的矛盾凸顯出來。
郵政編碼:200052 電話:021-63800152 傳真:021-63800151 京ICP備15010734號(hào)-10 技術(shù):網(wǎng)至普網(wǎng)站建設(shè)